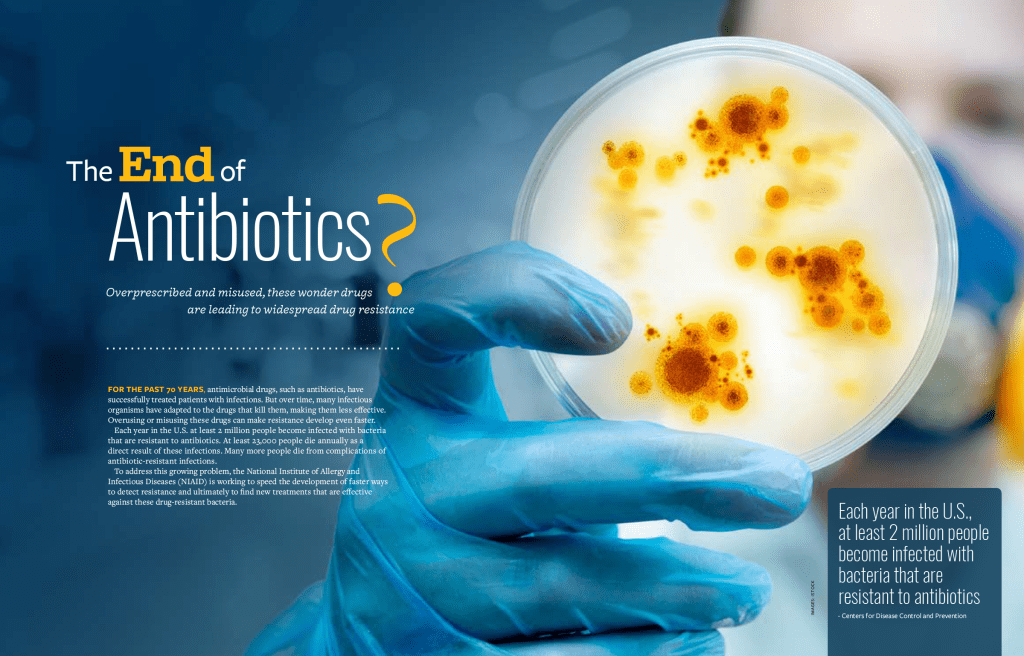

NIH MedlinePlus Magazine

Role: Senior Art Director (as an agent of Stratcomm Inc, Natick MA)
Scope: Concept and Layout Design, Graphic Illustration, Image Editing, Pre-Press, Digital Publishing.
Summary: NIH MedlinePlus Magazine is a trusted health information publication produced by the National Institutes of Health. It delivers accessible, evidence-based health content and resources to help readers make informed decisions about their health and wellness.
I inherited all design and content management responsibilities for the MedlinePlus Magazine project late in 2017. Our team delivered approximately 20 issues of the quarterly magazine between 2017 and 2022. Each issue required shaping content to make dense scientific and medical information approachable and engaging for the public. I executed reoccurring departments and unique features supported by info-graphics, illustrations, side-bars, and call outs that assisted comprehension and scan-ability with an emphasis on visual and technical accessibility.
Awards: Our team was honored to receive a 2018 APEX award for Publication Excellence for Most Improved in the Magazines, Journals & Tabloids category, recognizing our innovative editorial and graphic design work. We received a second Apex award in 2020 in the Websites category for our redesign of the NIH MedlinePlus magazine website.

See inside an issue of NIH MedlinePlus Magazine
See more past issues with my work (Fall 2017 – Fall 2021)
Our team also developed and launched the award-winning MedlinePlus Magazine online. The bilingual website was a major step in the clients mission to to provide accessible, evidence-based health information to the public. It features the latest medical research, expert health advice, and personal stories—making complex health topics accessible and engaging for a broad audience.
My role (across the same time frame as our work on the print edition) included art direction and digital design, asset creation and management, and content management and production.

The bilingual website was a major step in the clients mission to to provide accessible, evidence-based health information to the public. It features the latest medical research, expert health advice, and personal stories—making complex health topics accessible and engaging for a broad audience.






